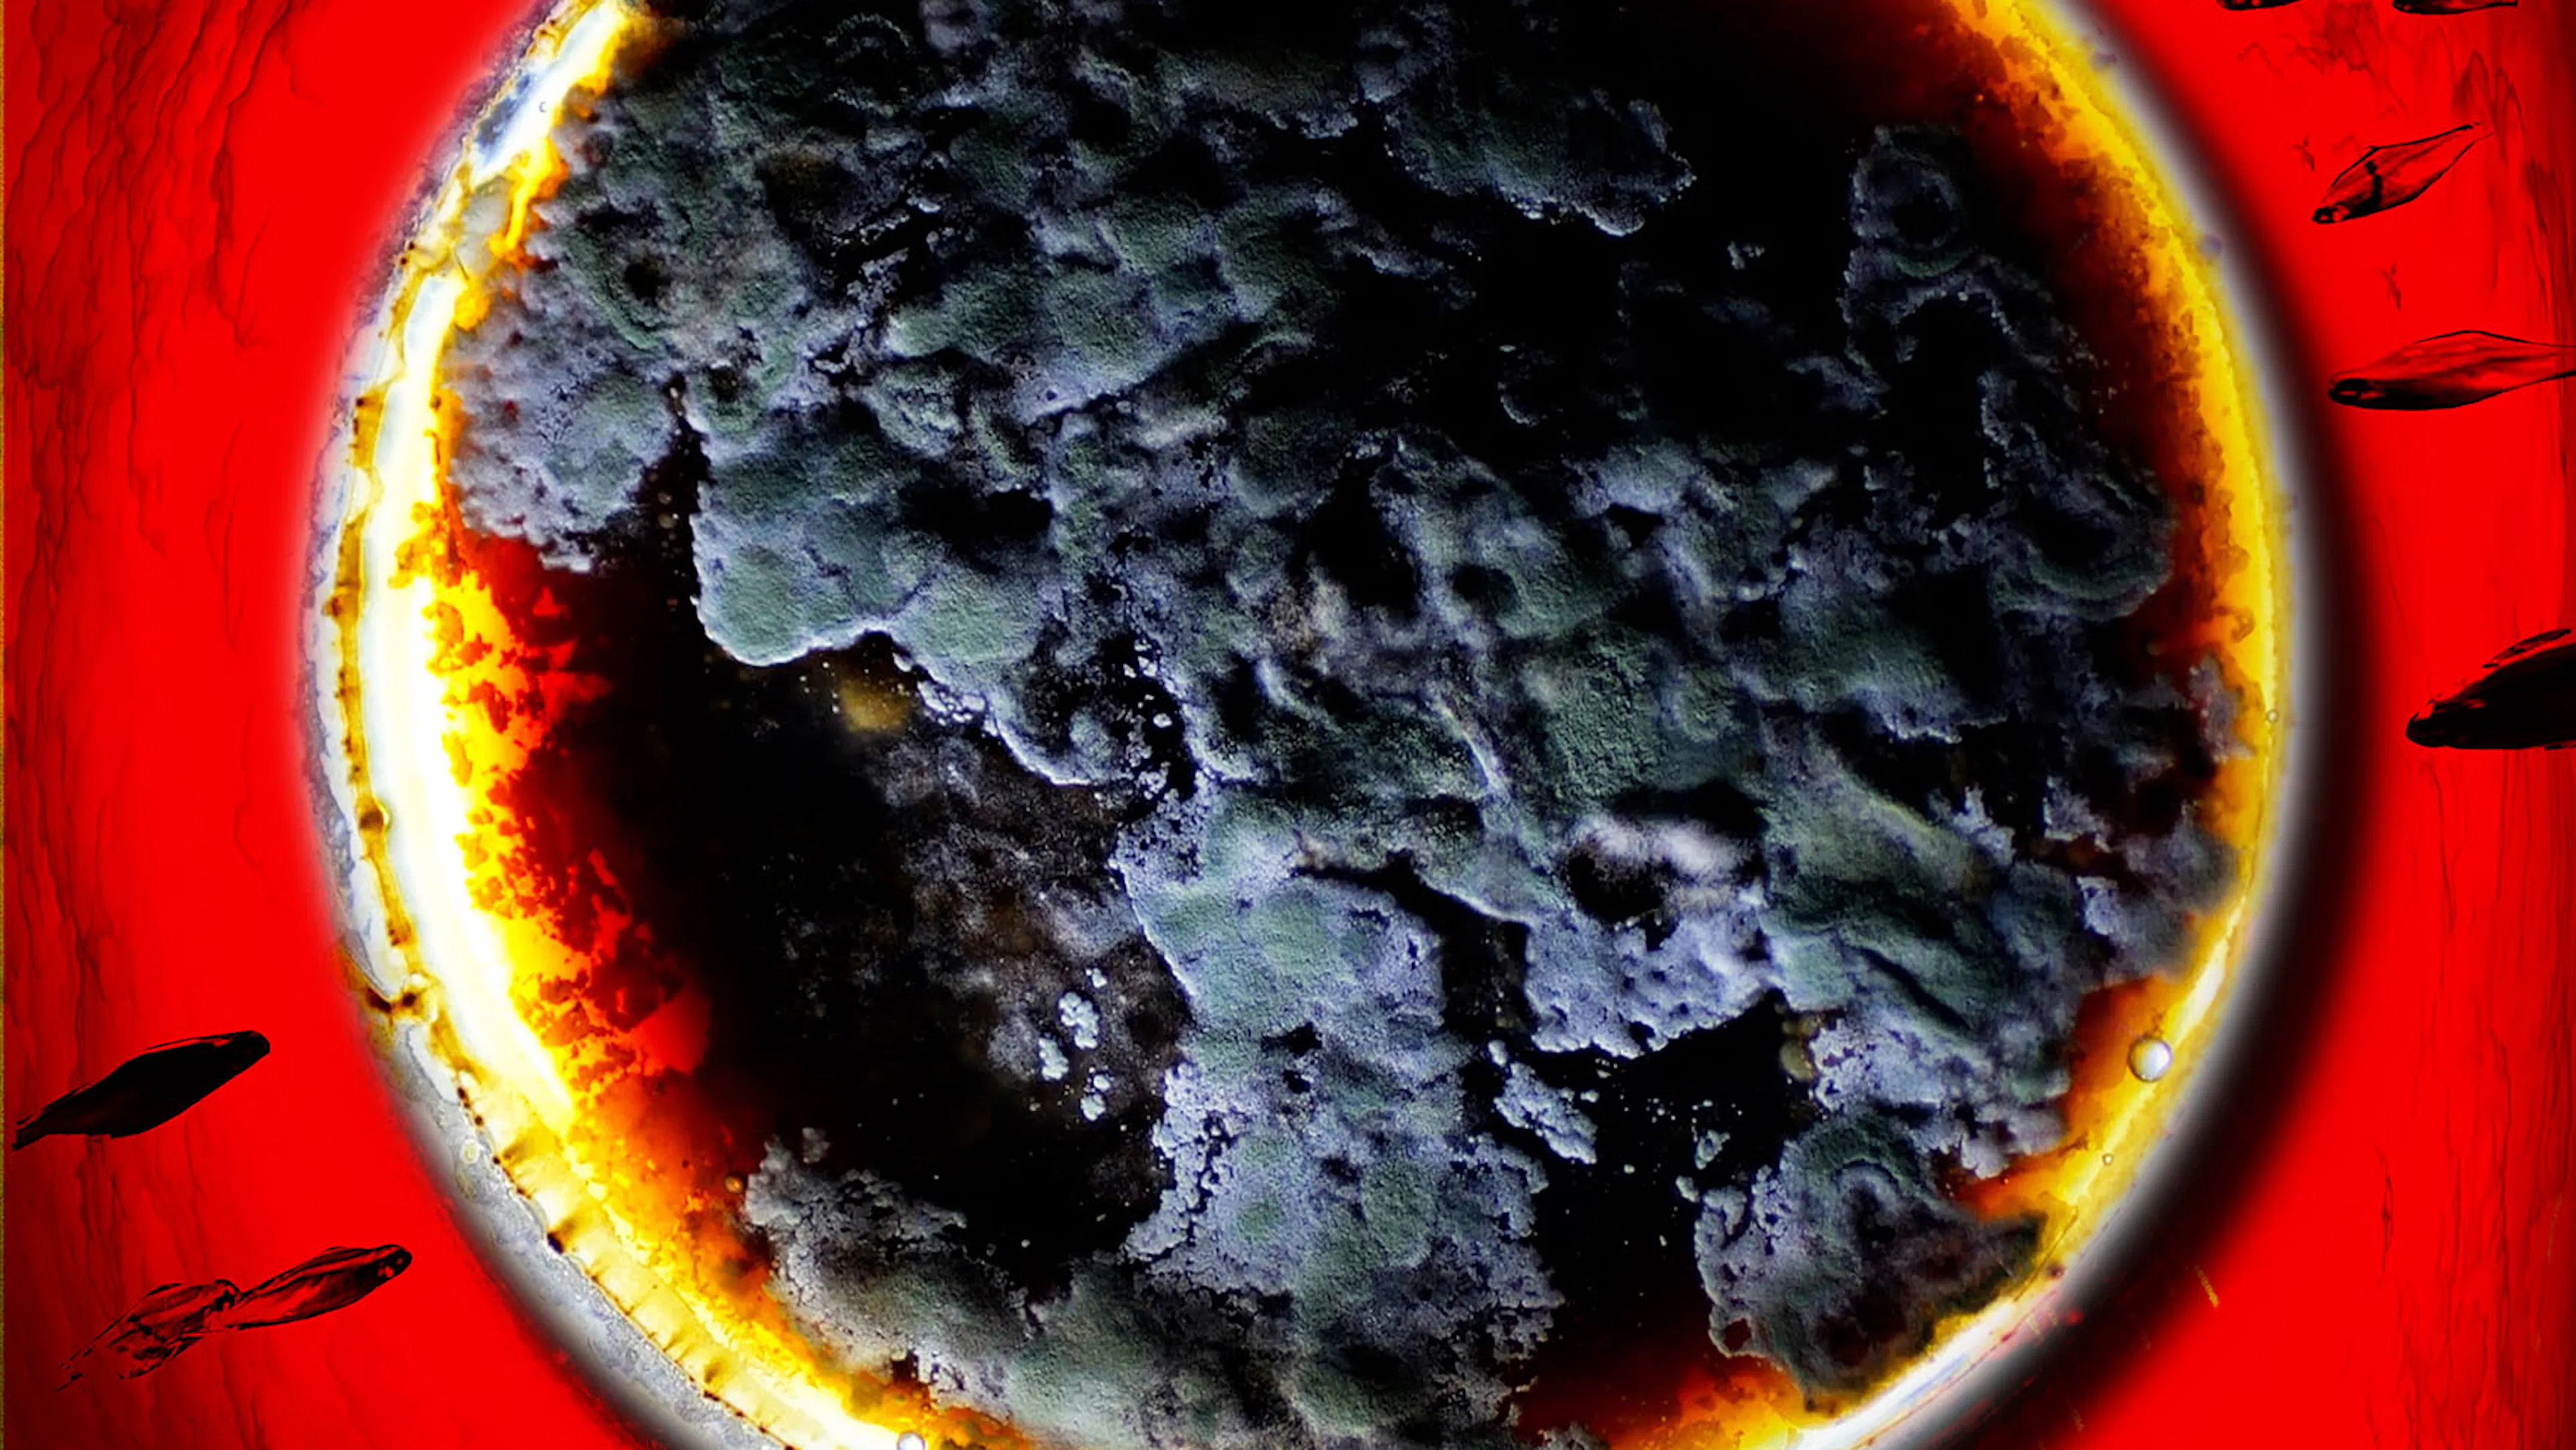

'You'ro Dance by Ark Park
6DOFamine
Republic of Korea
<'You'ro Dance> is an XR immersive performance that enables people with no dance experience to move and perform. By speaking words instead of learning choreography, participants generate AI-driven movement in real time, lowering the barrier to dance.